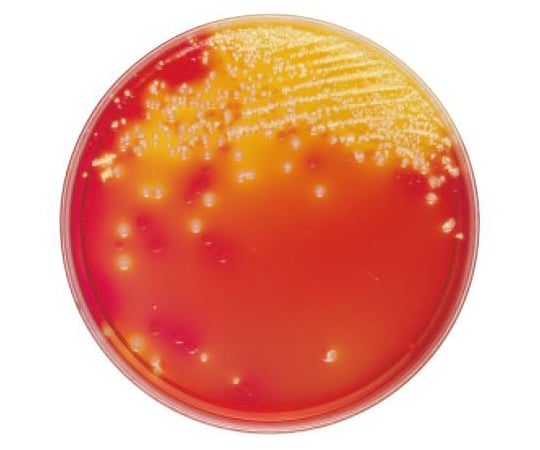
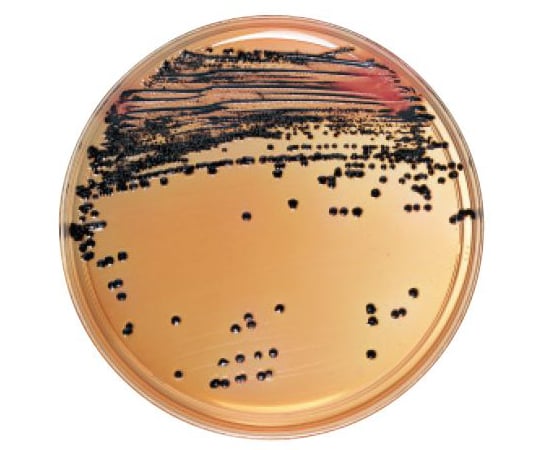

Dhl培地

4 1127 56 サニスペック生培地 Dhl寒天 100枚 アズワン As One

Nissui培养基 Nissui培养基

生培地 株式会社アテクト

語呂合わせ まとめノートで国家試験対策するなら臨床検査技師への道

塩化ナトリウムを含むサルモネラ菌検出用培地

微生物関連 食品 環境検査用培地 大腸菌 大腸菌群用 Kbm Dhl寒天培地 培地の販売 開発 製造は培地メーカーのコージンバイオ株式会社
DHL 寒天培地 特に Salmonella spp 、 Shigella spp などの腸内細菌の検出を容易にするため、従来のデ ソキシコレート培地を改良した培地です。 SS 寒天培地などでは一般に発育不良の.

Dhl培地. 今だけ送料無料! スタッドレスタイヤ ホイール 新品4本セット 165/50/15 。スタッドレスタイヤ ブリヂストン ブリザック vrx2 165/50r15 73q & ssr gtx03 5015 タイヤホイール4本セット 165/5015 bridgestone blizzak vrx2,スタッドレスタイヤ ブリヂストン ブリザック vrx2 165 タイヤ通販/50r15 激安タイヤ 73q. AdTrust FedEx for Fast Shipping Solutions Worldwide Prepare Your Shipment Today. DHL Agar 本培地は、病原性腸内細菌の選択分離用の培地で、特に Salmonella、Shigella、Yenterocolitica などの分離を目的とします。 乳糖分解菌だけでなく白糖分解菌も検出でき、.
②増菌培地 プレシオモナスに適した選択増菌培地はないので、直接分離培養を重視する。 ③分離培地 分離用培地は、SS寒天、DHL寒天を用いる。乳糖の分解が遅いため、SS寒 天上のコロニーは赤痢菌のそれに類似する。. 選択分離培地にSS寒天培地が含まれていません が、鶏肉のように夾雑菌(特にProteus属)が多い場 合、DHL培地では釣菌できない場合が多々あり、選 択性の強い、SS寒天培地も必要ではないかと考えま す。 SS寒天培地は臨床分野においてよく使用されています. AdUPS Is The World's Largest Package Delivery Company View All Shipping Options.
DHL寒天 (300g) MLCB寒天培地 (300g) LIM寒天培地 TCBS寒天培地 (300g) 食塩ポリミキシンブイヨン (100g) ブドウ球菌培地 (300g) マンニット食塩培地 (300g) マンニット食塩培地 (分包) 食塩卵寒天基礎培地 (300g) 食塩卵寒天基礎培地 (分包) NGKG寒天. (DHL栄 研化学),SS寒 天培地(SSOxoid),亜 硫酸ビ スマス寒天培地(BsAoxoid),XLD寒 天培地(XLD Oxoid)の5種 類ま た硫化水素産生性を指標としない 培地としてランバック寒天培地(RACHROMagar),ク ロモアガーサルモネラ培地(CASCHROMagar),ブ リリ アントグリーン寒天培地. の他のサルモネラ用培地を併用する。通常、糞便をサンプルとしてハーナテトラチオン酸塩培地 で増菌後、ノボビオシン( mg/L)加DHL寒天培地を用いて分離培養を行う。他の増菌用培地、 選択分離培地、免疫磁気ビーズ等の併用により、検出率は向上する。.
学校で習った培地の調製法は, 保存中の雑菌発育を防ぐという点では間違いではありません。胆汁酸塩が添加されている培地は, 加温溶解のみの培地と高圧蒸気滅菌できる培地とに使用法が指定されています。DHL寒天培地やマッコンキー寒天培地, デスオキシ. AdTrust FedEx for Fast Shipping Solutions Worldwide Prepare Your Shipment Today. 選択培地MacConkey培地(大腸菌検出)、DHL培地、SS培地(サルモネラ・シゲラ検出)基本は胆汁酸塩を加えグラム陽性菌を抑制、その他の阻害剤添加 大腸菌O 157選択培地ソルビトール加MacConkey培地(O 157はソルビトール非分解、遅れて分解)、SIB培地.
Dhl(ディーエイチエル)は、航空機を主体とした国際宅配便、運輸、ロジスティクスサービスを扱うドイツの国際輸送物流会社。 本社はドイツ連邦のボン。 事業展開国・地域数は228。 ドイツ国内および国外の宅配運送、ロジスティクスサービス等を複数社体制で提供する世界最大の. Feb 15, 13硫化水素産生菌は集落の中心が黒色になります。 (3) DHL寒天培地 DHLとはDesoxycholate Hydrogen sulfide Lactoseの略で SalmonellaおよびShigella の分離に使われていま. DHL寒天培地(ディーエイチエルかんてんばいち、Deoxycholatehydrogen sulfidelactose agar)とは、腸内細菌科の選択培地として利用される寒天培地の1つ。 サルモネラ属菌、赤痢菌、エルシニア属菌などの分離に用いられる 。 乳糖、白糖分解菌は赤色から桃色の不透明なコロニーを形成する。.
(DHL栄 研化学),SS寒 天培地(SSOxoid),亜 硫酸ビ スマス寒天培地(BsAoxoid),XLD寒 天培地(XLD Oxoid)の5種 類ま た硫化水素産生性を指標としない 培地としてランバック寒天培地(RACHROMagar),ク ロモアガーサルモネラ培地(CASCHROMagar),ブ リリ アントグリーン寒天培地. 学校で習った培地の調製法は, 保存中の雑菌発育を防ぐという点では間違いではありません。胆汁酸塩が添加されている培地は, 加温溶解のみの培地と高圧蒸気滅菌できる培地とに使用法が指定されています。DHL寒天培地やマッコンキー寒天培地, デスオキシ. DHL寒天培地「ダイゴ」 300g XLD寒天培地「ダイゴ」 300g セレナイト・シスチン基礎培地「ダイゴ」 300g テトラチオネート培地「ダイゴ」 300g ブリリアントグリン寒天培地「ダイゴ」 300g 亜硫酸ビスマス寒天培地.
バイタルメディア DHL寒天培地 略号 統一商品コード 包装 メーカー希望小売価格 有効期間 貯蔵方法;. Dhl寒天培地(顆粒) 「ニッスイ」 sds 300g ¥5,600室温・防湿 36ヵ月間 mlcb寒天培地 「ニッスイ」 sds 300g ¥5,0室温・防湿 36ヵ月間 xsal寒天培地(顆粒) 「ニッスイ」 sds 300g ¥16,000室温・防湿. DHLカンテン培地 EM-TG 作 成 平成10年12月22日 変 更 平成29年 3月10日 作成部隊等名 関東補給処用賀支処 1 総則 11 適用範囲 この仕様書は,陸上自衛隊において使用する市販品のDHL寒天培地について規定する。.
Created Date 1/25/06 PM. 100枚 15,000円 2ヶ月 4~8℃ 枚 3,000円 摘要;. Dhl寒天培地で乳糖または白糖のどちらか一方を分解する菌について 培地の色はピンクに? この培地はTSI培地とは少しことなります。 この培地の場合は培地の色ではなく、コロニーの色です。.
今回はDHL寒天培地について紹介する。 DHL寒天培地(Desoxycholate hydrogen sulfidelactose agar) 1.特徴 DHL寒天培地は坂崎らによりデオキシコレート寒天培地を改良したサルモネラ・赤痢菌の選択培地である。 本培地の特徴は鑑別用の炭水化. AdUPS Is The World's Largest Package Delivery Company View All Shipping Options. 二次増菌培養後の培養液01 mlをノボビオシン加dhl培地及びesサルモネラ寒天培地iiに塗抹し、24時間、37℃で培養しました(分離培養)。その後、4211と同様に鑑別同定しました。 4213 ふん便.
大便からは、DHL 寒天培地やマッコンキー寒天培地で分離する。Shigella はDHL 寒天培地やマッコンキー寒天培地上で、37℃1夜培養後、直径約1〜2mm の無色、半透明、湿潤な集落を形成する。DHL寒天培地上のShigella の集落を写真3 に示す。. 栄研化学 パールコア dhl寒天培地 300g ema85が寒天培地ストアでいつでもお買い得。当日お急ぎ便対象商品は、当日お届け可能です。アマゾン配送商品は、通常配送無料(一部除く)。. AdWe deliver to 1,000 destinations Worldwide!.
Salmonella I の大部分の株は、本培地上で硫化水素を産生し中心部黒色、周辺部 無色半透明の集落を作る。稀に硫化水素産生能が弱く、黒色が観察されない株がある。 一般にSS寒天よりDHL寒天の方が菌の発育がよく、観察しやすい。. DHL寒天培地「ダイゴ」 300g XLD寒天培地「ダイゴ」 300g セレナイト・シスチン基礎培地「ダイゴ」 300g テトラチオネート培地「ダイゴ」 300g ブリリアントグリン寒天培地「ダイゴ」 300g 亜硫酸ビスマス寒天培地. BD (Becton, Dickinson and Company) は、世界各国で、薬剤治療の改善、感染症診断の促進、および創薬の発展に従事する、メディカルテクノロジーのリーディングカンパニーです。.
AdWe deliver to 1,000 destinations Worldwide!. Mlcb、dhl、xld:黒色をサルモネラと推定する。 bgs:無色透明で培地色が赤色になったものをサルモネラと推定する。 chs:藤色をサルモネラと推定する。 esⅡ、sm2:ピンクをサルモネラと推定する。 (分離用寒天培地上でのサルモネラ集落の色についてはあらかじめ検証後に試験に使用すること). ② dhl 寒天培地 (坂崎ら:1960) ・ 乳糖、白糖を含む―サルモネラ・赤痢菌分離用の培地だが、他の培地より発育が良く、 とくに硫化水素産生菌が明瞭に発育し、黒色集落を形成する。 dhl 寒天培地上の乳糖分解性の違い (¾8 (0 ,æ.
Dhl寒天培地‘栄研’ 300g ema85 硫化水素産生性と糖分解能によるサルモネラ及びシゲラの分離用 大腸菌発育阻止作用がなくサルモネラとシゲラの発育がよい 衛生試験法・注解、食品衛生検査指針(微生物編)収載 パールコア®. Open a DHL Account Today. 各種硫化水素産生性指標培地 培地 DHL MLCB XLD 組成 1000ml 当たり 肉エキス 30g ペプトン 0g 乳糖 100g 白糖 100g デオキシコール酸Na 10g チオ硫酸Na 23g クエン酸Na 10g クエン酸鉄アンモニウム10g 中性紅 003g 寒天 150g pH74±02 酵母エキス 50g.

食品ネット分析室 サルモネラ検出用培地

原装进口日水改良tgc培养基 谷瀑环保

日水nissui培养基 组织培地 细胞培养用 制药行业 Nissui培养基

日水培养基 Nissui培养基

日本原装进口荣研株式会社 粉末培养基 易购安热销400 666 2192 Egoansmd11 新浪博客

南京市荣研化学粉末培厂家 供应荣研化学eiken粉末培地供应荣研化学eiken粉末培地e Mc85 一呼百应网

Amazon 日水製薬 粉末培地 顆粒タイプ Dhl寒天培地 300g 寒天培地 産業 研究開発用品 通販

Images Of Dhl寒天培地 Japaneseclass Jp

受注生産品 サルモネラ用 Dhl寒天培地 株式会社アテクト

Dhl寒天培地 Ss寒天培地 Macconkey寒天培地 国立病院機構 大阪医療センタ 佐子 肇 培地 は大きく分けると 特定の菌種だけでなくできるだけ多種類の菌種を発育させる 非選択培地 と特定の菌種のみを発育させる 選択培地 がある 非選択

腸管系細菌 細菌の検査 各論 神奈川県衛生研究所

サニスペック生培地medium サブローデキストロース寒天 培养 检查仪器 培养 分离 分析 培养 分离 分析 实验室仪器网

Dhl 寒天培地 輝生貿易eiken 產品中文介紹

腸管系細菌 細菌の検査 各論 神奈川県衛生研究所

Dox System Dox 60f Dox 30f Rapidly Evaluates The Total Number Of Microorganisms Coliforms And Escherichia Coli 4 Microbiological Medium Science Series

に サルモネラ菌を全面塗布後 透明プラスチック 片で覆い 310 K で 86 4 Ks 培養後の Dhl 培地を示す サル Download Scientific Diagram

食品用寒天平板生培地 Dhl 10枚 10袋 オリエンタル酵母工業

热销日本荣研寒天培地 栄研e Mc85培养基热线 价格 厂家 中国供应商

八雲総合病院 写真で見るシリーズ その1 感染対策室さんの日記

微生物学 グラム陰性桿菌

Amazon 日水製薬 生培地 ニッスイ分画 プレート 羊血液寒天 Dhl寒天培地 10枚 寒天培地 産業 研究開発用品 通販

腸管系細菌 細菌の検査 各論 神奈川県衛生研究所

Dhl寒天培地 Ss寒天培地 Macconkey寒天培地 国立病院機構 大阪医療センタ 佐子 肇 培地 は大きく分けると 特定の菌種だけでなくできるだけ多種類の菌種を発育させる 非選択培地 と特定の菌種のみを発育させる 選択培地 がある 非選択

Pdf Evaluation Of Antibacterial Activity Of Copper By Hydrogen Sulfide Producing Salmonella

腸管系細菌 細菌の検査 各論 神奈川県衛生研究所

腸管系細菌 細菌の検査 各論 神奈川県衛生研究所

Pr2686 Html

細菌検査のための 培地 基礎

サルモネラ 検査結果の例 石川ラボシステムズ

取扱を終了した商品です サニスペック生培地 Dhl寒天 枚入 4 1127 06 Axel アズワン

Xld培养基 产品详情 青岛海博生物

Images Of Dhl寒天培地 Japaneseclass Jp

腸管系細菌 細菌の検査 各論 神奈川県衛生研究所

食品検査用培地 サルモネラ属菌の分離用 Dhl寒天培地 タニモト Powered By イプロス

Dhl寒天培地の意味 用法を知る Astamuse

Examination Of Microbe

胆硫乳琼脂 Dhl 产品详情 青岛海博生物

材料別 組織 微生物検査 検査 診断matrix

日本栄研化学寒天培地e Mf21 300g 南京鹏控机电设备有限公司

細菌検査の最新情報 1ページ目 Mixiコミュニティ

細菌検査のための 培地 基礎

粉末培地medium 培养 检查仪器 培养 分离 分析 培养 分离 分析 实验室仪器网

湘央学園 Twitterissa 1年生の微生物学実習で腸内細菌の検索を行いました 4種類の未知検体中から1つ選び Dhl寒天培地 Ss寒天培地 Btb乳糖加寒天培地の3種類平板培地へ分離培養 湘央生命科学技術専門学校応用生物科学科のブログを更新しました T

サルモネラ属菌と微生物検査 食品の品質デザイナーをブランドに

荣研培养基e Mc35 E Mc35报价 价格 北京易购安科技有限公司 试剂库 生物在线lab On Web

Woa1 th1細胞誘導性細菌に対する抗菌組成物 Google Patents

寒天培地 寒天培地价格 寒天培地报价 中国供应商

日本荣研尿素培地e ma69 50ml 阿里巴巴

Dhl寒天培地 日本bd

細菌検査のための 培地 基礎

生培地 株式会社アテクト

サルモネラ属菌と微生物検査 食品の品質デザイナーをブランドに

細菌検査のための 培地 基礎

17 号 菌の検査方法 Astamuse

Amazon 極東製薬工業 生培地 バイタルメディア Dhl寒天培地 サルモネラシゲラの選択分離培養 入 2 6351 03 寒天培地 産業 研究開発用品 通販

Microbiology Round 亀田総合病院 感染症科
l Tm Dhl寒天培地 ベクトン ディッキンソン Axel アズワン

腸管系細菌 細菌の検査 各論 神奈川県衛生研究所

Kn エコノミー生培地 Dhl寒天培地 の販売価格と特徴 仕様 通販のテックジャム

平板生培地 グラム陰性桿菌用 製品リスト 日本bd

食品検査用培地 サルモネラ属菌の分離用 Ss寒天培地 タニモト Powered By イプロス

デゾキシコレート寒天培地の組成について

生培地 冷蔵 1セット 100個 アズワン 通販サイトmonotaro

取扱を終了した商品です サニスペック生培地 Dhl寒天 枚入 4 1127 06 Axel アズワン

取扱を終了した商品です サニスペック生培地 Dhl寒天 枚入 4 1127 06 Axel アズワン

Xld培养基 产品详情 青岛海博生物
特許 知財ポータル Ip Force
l Tm Dhl寒天培地 ベクトン ディッキンソン Axel アズワン

アスクル 極東製薬工業 生培地 バイタルメディア Dhl寒天培地 サルモネラシゲラの選択分離培養 入 5441 1箱 枚 2 6351 03 直送品 通販 Askul 公式

腸管系細菌 細菌の検査 各論 神奈川県衛生研究所

日水nissui培养基 组织培地 细胞培养用 制药行业 Nissui培养基

Dhl寒天培地 Ss寒天培地 Macconkey寒天培地 国立病院機構 大阪医療センタ 佐子 肇 培地 は大きく分けると 特定の菌種だけでなくできるだけ多種類の菌種を発育させる 非選択培地 と特定の菌種のみを発育させる 選択培地 がある 非選択
日本原装mem培地日水培养基 热线 400 666 2192 长途免费 易购安 新浪博客

大腸菌数定量 産業動物における細菌

食品検査用 平板培地 プレート

日水nissui培养基 组织培地 细胞培养用 制药行业 Nissui培养基

生培地 ポアメディア Dhl寒天 栄研化学 Misumi Vona ミスミ